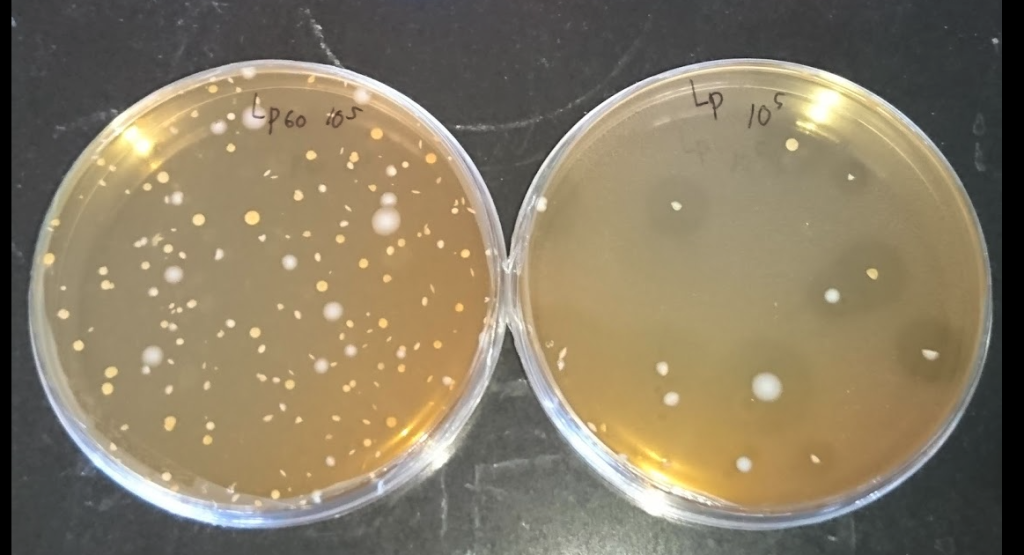
mrsa agar

Media MRS : Sejarah, Komposisi, dan Prosedur Isolasi Bakteri Asam Laktat
Genus Lactobacillus dikenal sebagai kelompok bakteri yang sangat menuntut nutrisi kompleks, atau dalam istilah mikrobiologi disebut fastidious. Bakteri ini tidak memiliki kemampuan biosintesis yang memadai untuk memproduksi semua vitamin dan asam amino yang mereka butuhkan untuk tumbuh. Oleh karena itu, mereka mutlak bergantung pada media pertumbuhan yang kaya akan nutrisi siap pakai.
Table Of Content
Pada pertengahan abad ke-20, para mikrobiolog menghadapi kendala besar dalam menumbuhkan bakteri ini secara konsisten. Media yang tersedia saat itu umumnya berbasis jus tomat (Tomato Juice Agar). Sayangnya, komposisi kimia jus tomat sangat bervariasi antar musim dan varietas, menyebabkan hasil eksperimen yang tidak dapat direproduksi (unreproducible).
Menjawab tantangan ini, pada tahun 1960, tiga ilmuwan—J.C. de Man, M. Rogosa, dan M.E. Sharpe—merancang formulasi sintetis baru yang mampu mendukung pertumbuhan Lactobacillus dengan subur sekaligus menekan pertumbuhan bakteri kontaminan. Formulasi inilah yang kini kita kenal sebagai media MRS, media umum kultivasi Bakteri Asam Laktat (BAL).

Komposisi dan Analisis Fungsi Bahan
Keunggulan formulasi MRS terletak pada keseimbangan presisi antara penyediaan nutrisi makro dan penggunaan agen selektif non-antibiotik. Berikut adalah bedah komposisi standar MRS Agar (pH akhir 6,2 ± 0,2):
| Bahan Penyusun | Jumlah (g/L) | Fungsi Spesifik |
|---|---|---|
| Proteose Peptone | 10,0 g | Sumber nitrogen organik dan asam amino. |
| Beef Extract | 10,0 g | Penyedia nitrogen tambahan dan karbon. |
| Yeast Extract | 5,0 g | Sumber vital vitamin B-kompleks yang mutlak dibutuhkan metabolisme BAL. |
| Glukosa (Dextrose) | 20,0 g | Sumber energi karbohidrat utama yang dapat difermentasi. |
| Polysorbate 80 (Tween 80) | 1,0 g | Surfaktan yang menyuplai asam lemak esensial (asam oleat) untuk metabolisme sel Lactobacillus. |
| Amonium Sitrat | 2,0 g | Agen selektif untuk menghambat bakteri Gram-negatif (seperti E. coli). |
| Natrium Asetat | 5,0 g | Agen selektif untuk menekan pertumbuhan bakteri Gram-negatif dan kapang, sekaligus buffer. |
| Magnesium Sulfat | 0,1 g | Sumber ion Mg2+, kofaktor enzim metabolik. |
| Mangan Sulfat | 0,05 g | Sumber ion Mn2+, kofaktor esensial. |
| Dipotassium Phosphate | 2,0 g | Sistem buffer untuk menjaga stabilitas pH. |
| Agar | 10,0 – 15,0 g | Agen pemadat (dihilangkan pada MRS Broth). |
Prosedur Pembuatan Media
Langkah Teknis Laboratorium
- Timbang bubuk media MRS komersial (misalnya Oxoid CM0361 atau Merck) sesuai instruksi pada label kemasan (umumnya berkisar 62 gram per liter akuades).
- Larutkan bubuk ke dalam akuades di dalam Erlenmeyer. Jika menggunakan bahan terpisah, pastikan Tween 80 ditambahkan terakhir karena sifatnya yang kental.
- Panaskan suspensi di atas hot plate stirrer sambil diaduk hingga mendidih. Pastikan agar larut sempurna dan media menjadi jernih berwarna kekuningan.
- Sterilisasi menggunakan autoklaf pada suhu 121°C selama 15 menit.
- Peringatan Kritis: Hindari pemanasan berlebih (overheating). Kandungan glukosa yang tinggi dalam media ini sangat rentan mengalami karamelisasi jika dipanaskan terlalu lama, yang dapat menurunkan pH dan menghambat pertumbuhan bakteri target.
Prosedur Isolasi Bakteri Asam Laktat
Isolasi BAL umumnya dilakukan dari sampel pangan fermentasi (seperti yogurt, kimchi, atau dadih) atau sampel probiotik. Karena BAL bersifat mikroaerofilik (tumbuh optimal dengan kadar oksigen rendah) atau anaerob fakultatif, teknik isolasi harus meminimalkan paparan oksigen.
1. Preparasi dan Pengenceran
- Siapkan larutan pengencer steril (Peptone Water atau NaCl 0,85%).
- Lakukan pengenceran bertingkat (serial dilution) dari sampel ($10^{-1}$ hingga $10^{-6}$) untuk mendapatkan jumlah koloni yang terhitung (30-300 koloni per cawan).
2. Inokulasi: Metode Tuang (Pour Plate)
Metode tuang (pour plate) lebih direkomendasikan dibandingkan metode sebar (spread plate) untuk isolasi Lactobacillus. Dengan metode ini, bakteri akan terperangkap di dalam matriks agar yang kondisinya lebih anaerob.
- Masukkan 1 mL sampel dari pengenceran yang dipilih ke dalam cawan petri steril yang kosong.
- Tuangkan ± 15-20 mL media MRS Agar steril yang telah didinginkan hingga suhu ± 45-50°C.
- Homogenkan dengan menggoyangkan cawan membentuk pola angka 8, lalu biarkan memadat.
- Opsional (Metode Overlay): Tuangkan lapisan tipis tambahan (5-10 mL) MRS Agar di atas media yang sudah padat. Lapisan ini berfungsi memblokir difusi oksigen dari udara, menciptakan kondisi mikroaerofilik yang ideal tanpa perlu inkubator khusus.
3. Inkubasi dan Observasi
- Inkubasi cawan dalam posisi terbalik pada suhu 37°C selama 48-72 jam.
- Penggunaan Anaerobic Jar (bejana anaerob) dengan gas pack penghasil CO2 sangat disarankan untuk hasil yang optimal.
- Karakteristik Koloni: Koloni Lactobacillus pada MRS agar biasanya tampak berwarna putih susu hingga krem, berbentuk bulat (sirkuler), cembung, dengan tepi yang rata, dan berukuran 1-3 mm.
Konfirmasi Isolat
Tumbuhnya koloni di media selektif seperti MRS hanyalah indikasi awal (presumtif). Verifikasi mutlak diperlukan melalui uji biokimia dasar:
- Pewarnaan Gram: Harus menunjukkan bakteri Gram-positif (ungu) berbentuk batang (basil) atau kokobasil.
- Uji Katalase: Harus menunjukkan hasil Negatif (tidak ada gelembung gas saat ditetesi H2O2). Sifat negatif katalase inilah yang membedakan BAL dari bakteri Gram-positif lain seperti Bacillus spp.
Daftar Pustaka
- De Man, J. D., Rogosa, M., & Sharpe, M. E. (1960). A medium for the cultivation of lactobacilli. Journal of Applied Bacteriology, 23(1), 130-135.
- Himedia Laboratories. (2019). Technical Data Sheet: Lactobacillus MRS Agar (M641).
- Salminen, S., von Wright, A., & Ouwehand, A. (2004). Lactic Acid Bacteria: Microbiological and Functional Aspects. 3rd Edition. CRC Press.